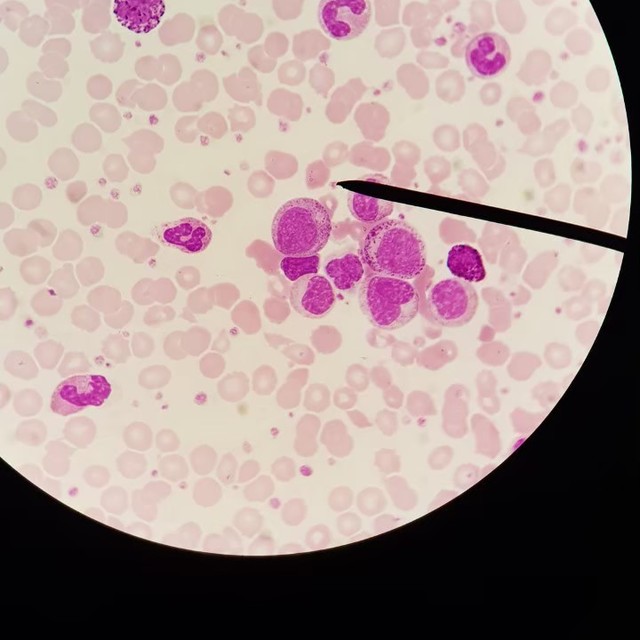

พี่ Ployykul จากเทคนิคการแพทย์มหิดล สอนชีววิทยา
กำลังศึกษา คณะเทคนิคการแพทย์ปี3 มหาวิทยาลัยมหิดลค่ะ
สนใจสามารถลองมาเรียนชีววิทยากันได้ หรือสงสัยเกี่ยวกับวิชาชีพหรือการเรียนของคณะนี้สามารถเข้ามาสอบถามได้เลยนะคะ
สามารถกำหนดเวลาเรียนได้เลย มาคุยกันก่อนได้นะคะ
พื้นที่ที่คุณครูท่านนี้สะดวกสอน
วิชาอื่นๆ ที่คุณครูสอน
รีวิวจากผู้เรียน
ยังไม่มีรีวิว